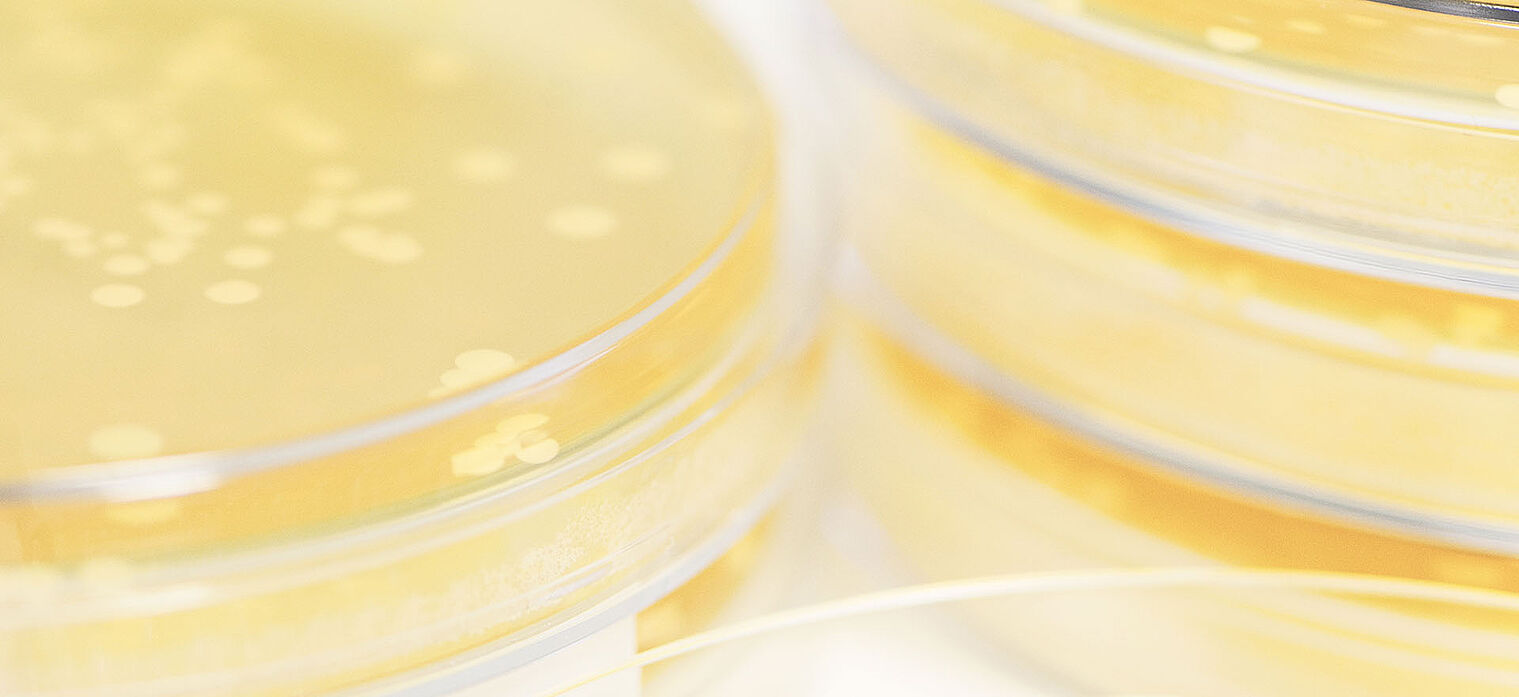

Immune system effects
The gastrointestinal tract takes a prominent part in the immune defense. In fact 80% of the immune system is located in the gut.
The information on this part of the website is intended only for health care professionals.I am an expert within the meaning of Act No. country xy. I herewith confirm that I am a professional according to this definition.
Unfortunately, as you are not a health care professional we cannot provide you this information.
A gastrointestinal flora in balance can enhance the immune health and contributes to and promotes a better general health.
Two trials with L. reuteri Protectis (BioGaia) have shown positive effects on prevention of infectious disease: Supplementation with BioGaia has a significantly positive effect on the incidence of common infections in children in day care and improve work-place healthiness by reducing short term sick-leave caused by respiratory or gastrointestinal infections.
A gastrointestinal flora in balance contributes to and promotes a better general health.
Limosilactobacillus reuteri Protectis has been shown to maintain digestive health and function and to keep the body’s natural defence.
1 chewable tablet or 5 drops daily
Effect of a probiotic infant formula on infections in child care centres.
Weizman Z, Asli G, Alsheikh A. (2005) Pediatrics 115:5-9.
Health protection with BioGaia Protectis in children.
L. reuteri significantly reduced
Increasing workplace healthiness with the probiotic Limosilactobacillus reuteri.
Tubelius et al., Environ Health 4:25 (2005). Health protection by BioGaia in adults.